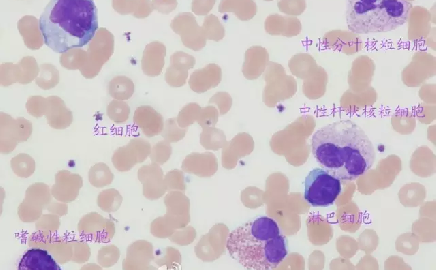

2016年05月03日
我国实施脊灰疫苗免疫新策略
阅读全文2016年05月03日
卫计委:支持有条件的医学院校加强儿科专业人才培养
阅读全文2016年04月29日
甲功报告怎么解读?都在这里了 !
阅读全文2016年04月29日
卫计委:十方面推进今年深化医疗改革工作
阅读全文2016年04月29日
财政部:今年各级财政继续对医疗卫生加大投入力度
阅读全文2016年04月29日
影响血培养阳性率的重要因素
阅读全文2016年04月29日
结核感染T细胞斑点试验在结核性心包炎诊断中的应用
阅读全文
2016年04月28日
令人眼花缭乱的肿瘤标志物
阅读全文
2016年04月28日
血液细胞家族大聚会
阅读全文艾迪康医学检验中心 © 版权所有 法律声明 浙ICP备07020270号-1 浙公网安备33010602009212号